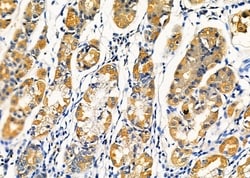
Invitrogen KCNK4 Polyclonal Antibody 100 &mu;L; Unconjugated:Antibodies,

missing translation for 'onlineSavingsMsg'
Learn More
Learn More
Invitrogen™ KCNK4 Polyclonal Antibody


Rabbit Polyclonal Antibody
Brand: Invitrogen™ PA5101761
This item is not returnable.
View return policy
Description
Antibody detects endogenous levels of total KCNK4.
Potassium channels play a role in many cellular processes including maintenance of the action potential, muscle contraction, hormone secretion, osmotic regulation, and ion flow. This gene encodes one of the members of the superfamily of potassium channel proteins containing two pore-forming P domains. The encoded protein homodimerizes and functions as an outwardly rectifying channel. It is expressed primarily in neural tissues and is stimulated by membrane stretch and polyunsaturated fatty acids.
Specifications
| KCNK4 | |
| Polyclonal | |
| Unconjugated | |
| KCNK4 | |
| K2p4.1; K2P4.1 potassium channel; Kcnk4; KT4.1; KT4.1b; LOW QUALITY PROTEIN: potassium channel subfamily K member 4; MLZ-622; Potassium channel subfamily K member 4; potassium channel, subfamily K, member 4; potassium channel, two pore domain subfamily K, member 4; potassium inwardly-rectifying channel subfamily K member 4; potassium inwardly-rectifying channel, subfamily K, member 4; potassium two pore domain channel subfamily K member 4; protein expressed in male leptotene and zygotene spermatocytes 622; Tex40; TRAAK; TRAAK1; TRAAKt; TWIK-related arachidonic acid-stimulated potassium channel protein; Two pore K(+) channel KT4.1; two pore K+ channel KT4.1; two pore potassium channel KT4.1 | |
| Rabbit | |
| Affinity chromatography | |
| RUO | |
| 116489, 16528, 50801 | |
| -20°C | |
| Liquid |
| Immunohistochemistry (Paraffin), Western Blot, Immunocytochemistry | |
| 1 mg/mL | |
| PBS with 50% glycerol and 0.02% sodium azide; pH 7.4 | |
| G3V8V5, O88454, Q9NYG8 | |
| KCNK4 | |
| A synthesized peptide derived from human KCNK4(Accession Q9NYG8), corresponding to amino acid residues E324-P374. | |
| 100 μL | |
| Primary | |
| Human, Mouse, Rat | |
| Antibody | |
| IgG |
Product Content Correction
Your input is important to us. Please complete this form to provide feedback related to the content on this product.
Product Title
Spot an opportunity for improvement?Share a Content Correction